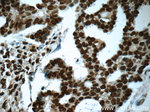
FUS/TLS Antibody in Immunohistochemistry (Paraffin) (IHC (P))

Search
Proteintech
FUS/TLS Monoclonal Antibody (3A10B5)
{{$productOrderCtrl.translations['antibody.pdp.commerceCard.promotion.promotions']}}
{{$productOrderCtrl.translations['antibody.pdp.commerceCard.promotion.viewpromo']}}
{{$productOrderCtrl.translations['antibody.pdp.commerceCard.promotion.promocode']}}: {{promo.promoCode}} {{promo.promoTitle}} {{promo.promoDescription}}. {{$productOrderCtrl.translations['antibody.pdp.commerceCard.promotion.learnmore']}}
产品信息
60160-1-IG
已发表种属
宿主/亚型
分类
类型
克隆号
抗原
偶联物
形式
浓度
保存条件
运输条件
产品详细信息
This antibody is a mouse monoclonal antibody raised against an internal region of human FUS. Initial reports from our customers suggest this new monoclonal FUS antibody (60160-1-Ig) is a useful tool in ALS and FTLD research. For more details, please see our blog article regarding the matter.
Immunogen sequence: QSSYSSYGQ SQNTGYGTQS TPQGYGSTGG YGSSQSSQSS YGQQSSYPGY GQQPAPSSTS GSYGSSSQSS SYGQPQSGSY SQQPSYGGQQ QSYGQQQSYN PPQGYGQQNQ YNSSSGGGGG GGGGGNYGQD QSSMSSGGGS GGGYGNQDQS GGGGSGGYGQ QDRGGRGRGG SGGGGGGGGG GYNRSSGGYE PRGRGGGRGG RGGMGGSDRG GFNKFGGPRD QGSRHDSEQD NSDNNTIFVQ GLGENVTIES VADYFKQIGI IKTNKKTGQP MINLYTDRET GKLKGEATVS FDDPPSAKAA IDWFDGKEFS GNPIKVSFAT RRADFNRGGG NGRGGRGRGG PMGRGGYGGG (52-400 aa encoded by BC026062)
靶标信息
This gene encodes a multifunctional protein component of the heterogeneous nuclear ribonucleoprotein (hnRNP) complex. The hnRNP complex is involved in pre-mRNA splicing and the export of fully processed mRNA to the cytoplasm. This protein belongs to the FET family of RNA-binding proteins which have been implicated in cellular processes that include regulation of gene expression, maintenance of genomic integrity and mRNA/microRNA processing. Alternative splicing results in multiple transcript variants. Defects in this gene result in amyotrophic lateral sclerosis type 6.
仅用于科研。不用于诊断过程。未经明确授权不得转售。